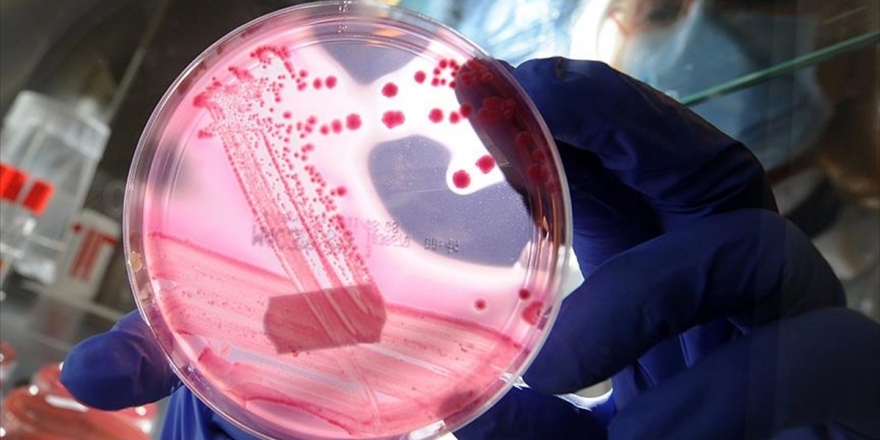
Sma Hastalığında Gen Tedavisine İlişkin Yeterli Klinik Deneme Bulunmuyor

CHP'den ABD'deki Olaylar İçin İlk Açıklama
ABD'de Trump taraftarlarının Senato'yu basmasına CHP'den ilk yorum geldi
ABD'de Donald Trump taraftarlarının Kongre'yi basması ve çıkan olaylarda 4 kişinin hayatını kaybetmesi dünyayı sarsarken Ankara'dan da "İtidal çağrısı" gündeme gelmişti. Anamuhalefet partisi CHP'den ilk değerlendirme de geldi. CHP Genel Başkan Yardımcısı ve Parti Sözcüsü Faik Öztark da, olayı, demokrasiye yapılmış 'sivil darbe' diye nitelendirdi.
Sosyal medya hesabından açıklama yapan Öztrak şunları kaydetti:
"Dün, ABD'de seçimi kaybedenlerin "seçmen iradesine", "demokrasiye" ve "hukukun üstünlüğüne" yönelik sivil darbe girişimini şiddetle kınıyorum.
#ABDdarbe"
Dün, ABD'de seçimi kaybedenlerin "seçmen iradesine", "demokrasiye" ve "hukukun üstünlüğüne" yönelik sivil darbe girişimini şiddetle kınıyorum.#ABDdarbe
— Faik Öztrak (@faikoztrak) January 7, 2021

Türkçe karakter kullanılmayan ve büyük harflerle yazılmış yorumlar onaylanmamaktadır.